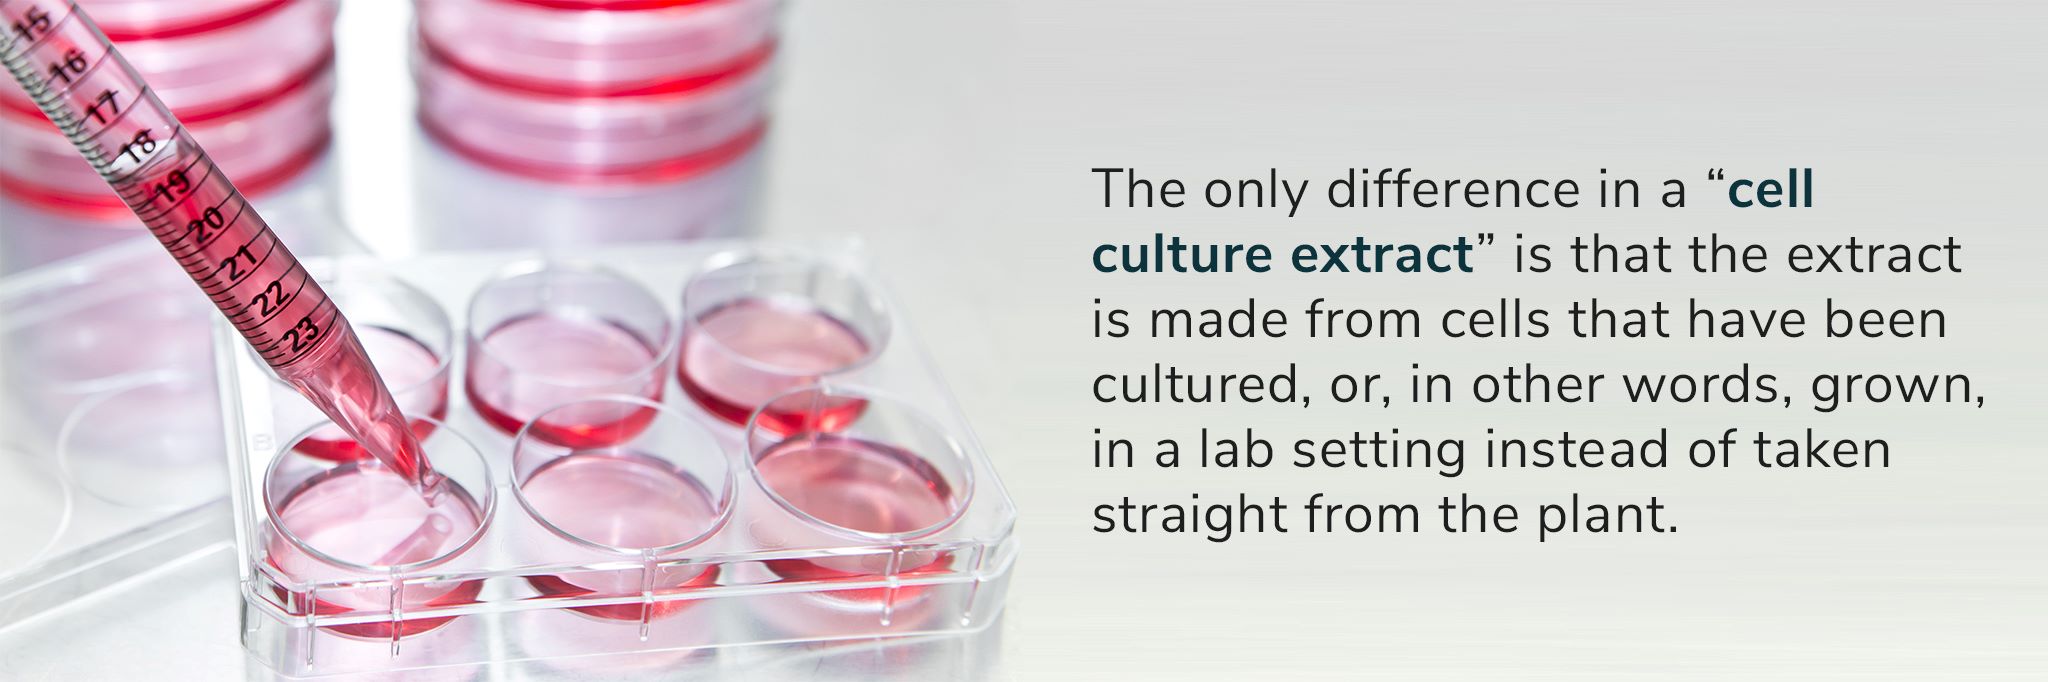

Apple Fruit Skincare Products
We all know the old saying “an apple a day keeps the doctor away” but could it also keep the signs of aging away? Apple's skincare products have a reputation for being good for us and with good reason!
These delicious fruits are packed with all kinds of beneficial things like vitamins, amino acids, minerals, flavonoids, and antioxidants.
Although their ability to improve our internal health is pretty common knowledge, what about our external health? It just so happens that apples can, indeed, do it all.
The topical use of apple extracts has also proven itself worthy of everyday use.
Not only do the extracts from this fruit give us better-looking skin, but they also give us truly healthier skin; right down to the cellular level!
We use two different kinds of extracts in our products, each with its benefits.
Read on to get a closer look at what these extracts are and the many ways that they can lead to healthy and radiant skin!
Our Choice Apple Extracts
There are quite a few types of apple extracts, the difference between them depends not only on the type of apple used but also on the part(s) of the apple that the extract is made from.

Malus Domestica Fruit Cell Culture Extract
The first extract in our arsenal is the Malus Domestica Fruit Cell Culture Extract. We know, a bit of a mouthful… This extract, however, doesn’t come from just any old apple tree.
The apple itself is more commonly known as the Swiss Apple and comes from a very rare tree called Uttwiler Spätlauber that is native to the Swiss Alps.
The tree is so rare that the extract isn’t even from the apple itself because the tree is endangered and protected.
As the name implies, the extract is instead made from a cell culture of the Swiss apple.
Using the cell cultures allows for a steady supply of these cells without driving the Uttwiler Spätlauber tree to extinction.
Pyrus Malus Fruit Extract
This extract, on the other hand, is made from your everyday run-of-the-mill red apple.
Unlike the Malus Domestica extract, this one is made directly from the actual fruit instead of cell culture.
Although its origins aren’t quite as exotic and impressive, this extract is still sure to treat your skin luxuriously!
Apple Cell Culture Extract vs Fruit Extract
What is a Cell Culture Extract?
To create a typical cell extract from a plant, scientists first have to damage the plant. By doing this, they start the plant’s healing process.
As the plant sends stem cells to the damaged area to begin the healing process, scientists harvest these stem cells and store them.
The scientists then carefully break the exterior walls of the cell.
Once the cell walls have been broken, the contents of the cell can then be extracted.
These inner parts of the cell that have been harvested are what is referred to as the “cell extract.”
Health Benefits of Apple
Pretty much everyone understands that apples are good for them, but many people underestimate just how healthy they are.
Apples are packed with vitamins, minerals, fiber, polyphenols, and antioxidants.
Apples have been proven to fight diseases like cancer, diabetes, and heart disease, as well as, protect the brain from Alzheimer’s and Parkinson’s.

With so many benefits to our internal well-being, it shouldn’t come as any surprise that the extracts made from this incredible fruit can also benefit our skin when applied topically.
Although both of these extracts come from apples, the difference in the types of apples causes each extract’s topical benefits to varying a bit.
Beneficial Compounds in Apples:
- Vitamin A
- Vitamin B
- Vitamin C
- Vitamin E
- Vitamin K
- Antioxidants
- Niacin
- Folate
- Potassium
- Fiber
- Quercetin
- Flavanols
- Catechins
- Anthocyanins
Topical Applications
Increase Longevity of Skin Stem Cells

This extract has been shown to prolong the life of our skin’s stem cells.
Stem cells only make up about 2-7% of our skin cells but are responsible for the constant renewal of our skin through the creation of new cells.
All of the cells in our body go through a life cycle much shorter than our own and at the end of the cell’s life cycle, it dies and is replaced by new cells.
As we age, the ability of our stem cells to produce new cells becomes less efficient and eventually stops.
As fewer new cells are created, the aged and dying cells begin to outnumber them, this leads to a decline in the skin’s appearance.
By prolonging the life of our skin’s stem cells, we can put off the onset of visibly aged skin, giving us younger-looking skin for a longer time.
UV Protection

The second-largest contributor to aging skin is caused by environmental factors like air pollutants and too much sun exposure.
The sun’s damaging UV radiation can cause free radicals to form on our skin.
These free radicals are known to prematurely age the skin, leading to wrinkles, fine lines, and sagging skin.
This extract has a high antioxidant content which can be effective in removing and neutralizing harmful free radicals from the skin.
A recent study proved the extract’s ability to protect the cells from UV damage.
They tested its effectiveness by placing two groups of cells under intense UV light.
The first group was an untreated group of cells and showed a loss of about 50% of the cells after the UV exposure.
The second group of cells was treated with the apple extract and only showed the loss of a few cells after an equal dose of UV radiation.
Maintain Skin Strength and Elasticity

Although this extract has been shown to increase the longevity of our stem cells, they only make up a very small percentage of our skin cells.
Luckily, it also increases the productivity and longevity of cells called fibroblasts, which make up the majority of our skin cells.
These cells are responsible for making proteins like collagen and elastin that maintain the shape and appearance of our skin, as well as, play a major role in the wound healing process.
As we age, our body naturally begins to lose these proteins faster and produce less of them.
The apple extract has been shown to not only reduce the effects that aging has on these cells but even reverse them to some degree!
Reduce Wrinkles and Fine Lines

The combination of this extract’s antioxidants, as well as, its ability to restore the function of both our stem cells and fibroblast cells makes it a triple threat for fending off wrinkles and fine lines!
While the antioxidants remove free radicals that can cause the skin to prematurely age, the increased presence and function of both cell types will lead to more of the skin proteins collagen and elastin.
This will keep the skin from sagging, increase the skin’s density, and give the skin an overall younger appearance.
Malus Domestica Cell Culture Extract Topical Benefits:
- UV protection
- Antioxidant
- Reduce wrinkles
- Reduce fine lines
- Increase skin elasticity
- Tighten skin
- Increase skin density
- Improve wound healing
Pyrus Malus Fruit Extract Uses:
Anti-aging

Like the Malus Domestica extract, this extract also has a high content of antioxidants.
This makes it useful for preventing free radicals from forming on the skin, as well as, removing free radicals that are already on the skin.
These free radicals can come from UV radiation, pollution, and other environmental sources.
By keeping our skin free of these damaging substances we can prevent premature aging of the skin.
Moisturizer

This extract is considered a “humectant” which means it helps the skin to retain its moisture.
It contains a fiber known as pectin which studies have proven can bolster and improve the functioning of our skin’s natural barrier.
By maintaining the skin’s natural barrier, we can prevent it from losing essential moisture.
Fights Acne

This powdered extract is known to have several properties that can combat acne.
As previously mentioned, the extract can improve our skin’s natural barrier.
This not only helps to maintain the proper levels of skin moisture to prevent acne but also prevents bacteria and other irritants that can cause blemishes from penetrating the skin.
Pyrus Malus extract is also known to have astringent and exfoliating properties that work together to clean the skin and tighten the pores.
By tightening the pores, the extract also helps to reduce the amount of sebum that the pores secrete.
This can be particularly useful for people who suffer from an oily complexion.
Promotes Skin Growth

In a similar fashion as the Malus Domestica extract, this extract also increases the productivity of the fibroblast skin cells.
By increasing these cells’ production of collagen and elastin, topical applications of the Pyrus Malus extract can increase skin density, reduce skin sagging, increase skin elasticity, and reduce wrinkles and fine lines!
Miscellaneous Uses of Pyrus Malus Extract
Although this extract can benefit the skin in many ways, it is sometimes added to cosmetics to benefit the product itself, rather than the skin.
This extract can also be used as:
- Fragrance
- Binding agent for ingredients
- Product thickener
- Stabilizer to prevent product separation
Pyrus Malus Fruit Extract Topical Uses:
- Moisturizer
- UV protection
- Increase skin elasticity
- Tighten skin
- Reduce wrinkles
- Antioxidant
- Reduce fine lines
- Reduce acne
- Skin conditioner
- Increase skin density
- Tighten pores

